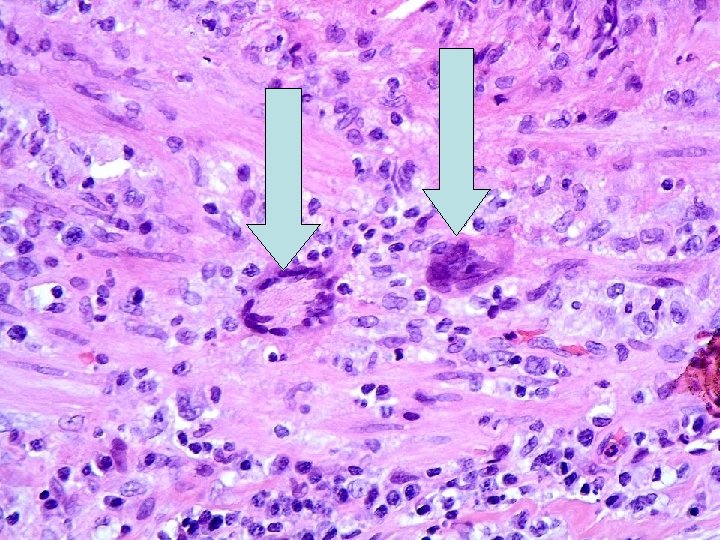

Normal TA intima media adventitia Bluish curly line

Normal TA

intima media adventitia

Bluish curly line is internal elastic lamina

intima media Elastin Von Gieson (EVG) stained internal elastic lamina-normal.


adventitia media


INTIMA MEDIA

EVG STAIN


Temporal arteritis

Temporal arteritis Idiopathic, granulomatous vasculitis of large or medium sized elastic arteries. SKIP LESIONS Predilection for superficial temporal artery, but can affect cerebral arteries, carotids, coronary arteries, aorta, renal arteries etc… Pathogenesis-actinically damaged elastic tissue-trigger cell-mediated immune response ? Infection? Histology-with and without giant cells. Adventitial acute and chronic inflammation with involvement of media (muscle layer). Fragmentation of internal elastic lamina. Giant cells at sites of internal elastic lamina rupture (not always). Inflammatory oedema of intima, with stenosis of lumen.

American College of Rheumatology Criteria Based on the 1990 American College of Rheumatology criteria for classification of giant cell arteritis, 3 of the following 5 items must be present: n n n Development of symptoms in patients older than 50 years New onset of headache or localized head pain Temporal artery tenderness to palpation Decreased pulsations not related to arteriosclerosis of cervical arteries ESR greater than 50 mm/h

Temporal artery biopsy No evidence base for how long biopsy should be. The longer the better as maximises chances of catching skip lesion. Target biopsy to painful segment-important. During handling in pathology lab- serial sections are cut through the entire specimen (with or without elastin stains), to increase chance of picking up skip lesion.

Temporal artery biopsy Minimum distance between skip lesions =350 microns (autopsy data). Positive biopsy rate in pre-steroid cases 30 -70 % of cases (depending on which papers read) (usually 6070%). Positive biopsy rate after week of steroids-20%-probably due to decreased sampling efficiency as pain is reduced. Can detect trans-mural scarring in healed arteritis. Seeing scarring is not an indication to stop steroids.

Why biopsy ? Biopsy often done for medicolegal reasons to confirm diagnosis. Helpful when positive. Steroid treatment is not an easy undertaking. . numerous side effects. Therefore positive biopsy justifies continued treatment.
- Slides: 18